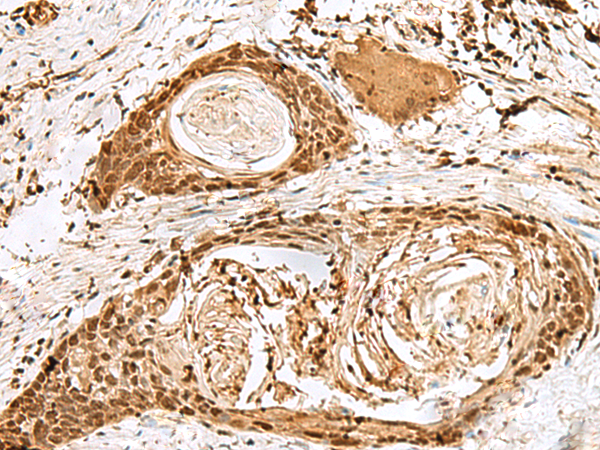
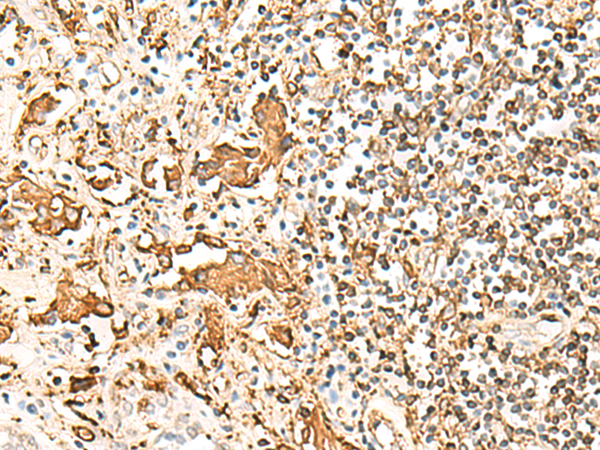

-
分类: 科研抗体货号: P09887别名: ZNF47; ZSCAN15应用: IHC反应种属: Human
-
分类: 科研抗体货号: P09869别名:应用: IHC反应种属: Human
-
分类: 科研抗体货号: P09880别名: PDIR应用: WB,IHC反应种属: Human, Mouse, Rat
-
分类: 科研抗体货号: P09886别名: CHED; CHED1; CHED2; PPCD1; ZNF339; EUROIMAGE566589应用: WB,IHC反应种属: Human, Mouse
-
分类: 科研抗体货号: P09898别名: PKE; YANK3应用: IHC反应种属: Human, Mouse
-
分类: 科研抗体货号: P09879别名: IDDM1; CELIAC1; HLA-DQB应用: IHC反应种属: Human
-
分类: 科研抗体货号: P09884别名: DR4; DRB4; HLA-DR4B应用: WB,IHC反应种属: Human
-
分类: 科研抗体货号: P09897别名: SNAP43; PTFgamma应用: IHC反应种属: Human
-
分类: 科研抗体货号: P09877别名: PTD017; S18amt; C6orf14; HSPC183; MRPS18-2; HumanS18a; MRP-S18-2应用: WB,IHC反应种属: Human
-
分类: 科研抗体货号: P09883别名: SS1; DRB1; HLA-DRB; HLA-DR1B应用: WB,IHC反应种属: Human

鄂公网安备42018502007531号
鄂公网安备42018502007531号

